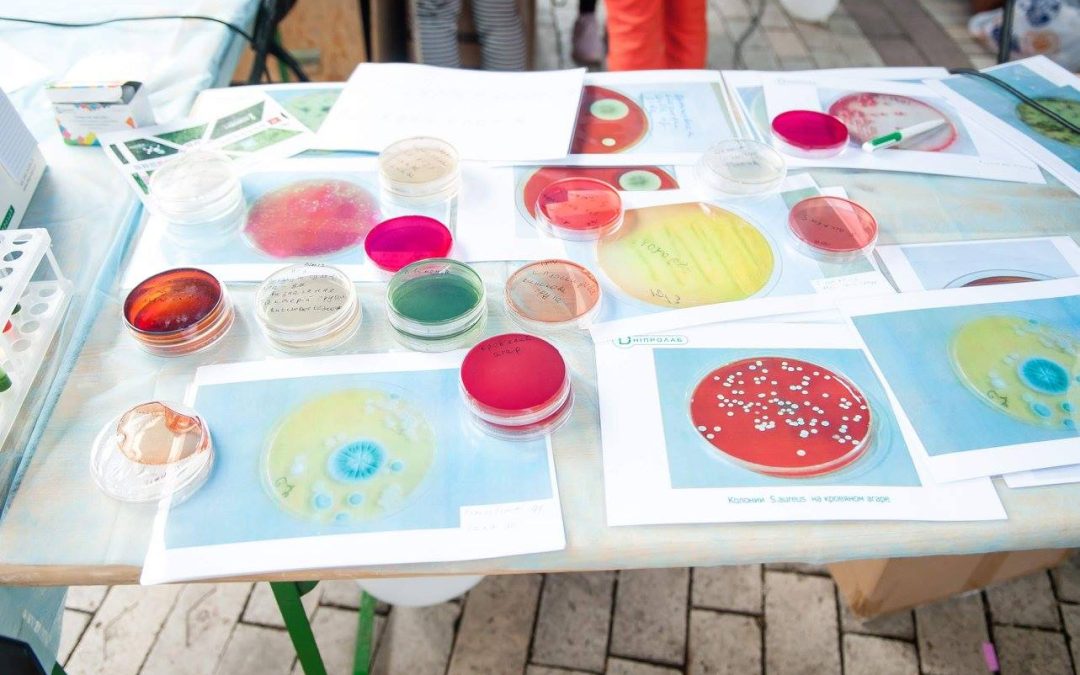

Новини
- Autodesk Fusion 360 для 3D-друку: навчальний онлайн-курс
- Крафтярі: дослідження локальних майстрів
- Виклики для вирішення хакатону ActInSpace 2026: космос для Землі та людства
- Виклики для вирішення хакатону ActInSpace 2026: лети до Місяця і далі
- Проєкти для натхнення учасникам космічного хакатону ActInSpace 2026
- Виклики для вирішення хакатону ActInSpace 2026: бізнеси повсякденного життя
- Досвід використання принтера Bambu Lab A1 minі: відгук користувача Lom Lomu з Facebook-групи 3DprintUA
- Виклики для вирішення хакатону ActInSpace 2026: стань новим гравцем у космосі #Space 4.0